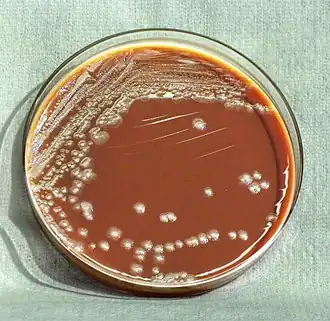
Description de cette image, également commentée ci-après

Yersiniaceae
| Domaine | Bacteria |
|---|---|
| Règne | Pseudomonadati |
| Phylum | Pseudomonadota |
| Classe | Gammaproteobacteria |
| Ordre | Enterobacterales |
Les Yersiniaceae sont une famille de bacilles Gram négatifs de l'ordre des Enterobacterales. Leur nom provient de Yersinia qui est le genre type de la famille.
Taxonomie
Cette famille est créée en 2016 lors de la réorganisation de l'ordre des Enterobacterales par M. Adeolu et al. sur la base de travaux de phylogénétique moléculaire[1]. Elle se compose de genres bactériens auparavant rattachés aux Enterobacteriaceae sur la base de critères phénotypiques.
Le nom correct complet (avec auteur) de ce taxon est Yersiniaceae Adeolu et al. 2016[2].
Le genre type est Yersinia van Loghem 1944[2].
Étymologie
L'étymologie de cette famille est liée à son genre type, le genre Yersinia et se décompose ainsi : Yer.si.ni.a.ce’ae. N.L. fem. n. Yersinia, genre type de la famille; L. fem. pl. n. suff. -aceae, suffixe définissant une famille; N.L. fem. pl. n. Yersiniaceae, la famille dont le genre type est Yersinia[2].
Liste de genres
Selon la LPSN (8 juin 2025)[2], il existe genres publiés de manière valide :
- Chania Ee et al. 2016
- Chimaeribacter Rossi & Fisher 2020
- Ewingella Grimont et al. 1984
- Rahnella Izard et al. 1981
- Rouxiella Le Flèche-Matéos et al. 2015
- Samsonia Sutra et al. 2001
- Serratia Bizio 1823
- Yersinia van Loghem 1944 – genre type
Le genre « Ca. Fukuatsuia » Manzano-Marín et al. 2017 est en attente de publication valide et dont le nom est considéré comme pro-correct[2].
Notes et références
- ↑ Adeolu M et al. « Genome-based phylogeny and taxonomy of the ‘Enterobacteriales’: proposal for Enterobacterales ord. nov. divided into the families Enterobacteriaceae, Erwiniaceae fam. nov., Pectobacteriaceae fam. nov., Yersiniaceae fam. nov., Hafniaceae fam. nov., Morganellaceae fam. nov., and Budviciaceae fam. nov. » Int J Syst Evol Microbiol. 2016;66(12):5575-5599. Accès libre.
- 1 2 3 4 5 List of Prokaryotic names with Standing in Nomenclature (LPSN), consulté le 8 juin 2025.
Liens externes
- (en) Catalogue of Life : Yersiniaceae Adeolu et al., 2016 (consulté le )
- (fr + en) EOL : Yersiniaceae (consulté le )
- (fr + en) GBIF : Yersiniaceae (consulté le )
- (fr) INPN : Yersiniaceae Adeolu, Alnajar, Naushad & Gupta, 2016 (TAXREF) (consulté le )
- (en) IRMNG : Yersiniaceae Adeolu et al. 2016 (consulté le )
- (en) LPSN : Yersiniaceae Adeolu et al. 2016 (consulté le )
- (en) NCBI : Yersiniaceae (taxons inclus) (consulté le )
- (en) OEPP : Yersiniaceae (consulté le )
- (en) Taxonomicon : Yersiniaceae Adeolu et al., 2016 (consulté le )
- (en) WoRMS : Yersiniaceae Adeolu, Alnajar, Naushad & Gupta, 2016 (+ liste espèces) (consulté le )
- Portail de la microbiologie